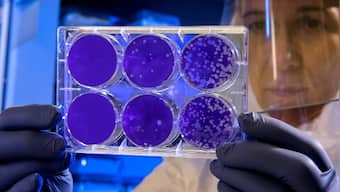

Hantavirus got much public attention earlier this year when a man in China died of an infection caused due to a strain of this virus. Though the majority of the world had first heard of the virus in March 2020, hantavirus is not a new virus. The first-ever hantavirus isolate was obtained in India in 1964. The virus outbreaks occurred in 1993 and 2012 in the US, causing hemorrhagic fever. Up until now, it was known that hantavirus spreads mostly through mice in Europe (Puumala and Dobrava-Belgrade viruses). The Seoul virus, which is more common in Asia, spreads through rats. It is also found in some species of Norway rats. However, a study done in Germany now shows that rats (both wild and domestic) in other parts of the world can also spread hantavirus. The findings of the study, published in the journal Emerging Infectious Diseases by the Centers for Disease Control and Prevention (CDC), USA, indicate that the virus seems to be able to spread and be present in rats in anywhere in the world (mostly through trade) and hence, special caution needs to be taken while trading in or dealing with these rodents. Rat vs mice Rats and mice are both types of rodents found in several areas around the world. Though they look similar superficially, rats generally have a thick and hairless tail, large feet and small ears. On the other hand, mice have a long slender tail, large ears and are covered in small hair with a comparatively lighter shade on their belly. Hantavirus infection As per the CDC, old-world hantavirus is found in Europe and Asia and lead to hemorrhagic fever with renal syndrome (HFRS), while the new world hantavirus causes hantavirus pulmonary syndrome (HPS). HFRS has symptoms similar to COVID-19 and is characterized by fever, nausea, chills, back pain, abdominal pain, headache and blurred vision. Low blood pressure and acute kidney failure occur afterwards. HPS presents as fever, muscle pain, headache, dizziness, abdominal pain and diarrhea beginning and, later on, cough and shortness of breath. The latest study As per the latest study, hantavirus disease caused by Seoul virus is often misdiagnosed outside Asia as it is not endemic there and often causes less severe disease than the hantavirus found in Europe. However, in 2019, the Seoul virus was found in a woman and her pet rat in Germany. The woman developed hepatopathy, gastroenteritis and acute kidney injury over the course of her disease. The disease was identified by a pan-hantavirus RT-PCR. The woman reported that her rat has not been out of her apartment. Though, both the woman and the rat showed the presence of the same virus, suggesting that the woman may have gotten the virus from the rat. Further testing showed that the virus was similar to the one found in the UK and Netherlands. The study authors indicated that more studies are needed to better understand the spread of Seoul hantavirus in Germany to assess the risk to pet owners as well as the general public. For more information, read our article on World’s deadliest viruses and where COVID-19 fits in this scheme . Health articles in Firstpost are written by myUpchar.com, India’s first and biggest resource for verified medical information. At myUpchar, researchers and journalists work with doctors to bring you information on all things health.
Hantavirus: German study suggests any rat could get Seoul virus, transmit it to humans
Myupchar
• November 13, 2020, 15:22:00 IST
Hantavirus got much public attention earlier this year when a man in China died of an infection caused due to a strain of this virus, the first isolate of which was found in India in 1964
Advertisement
)
End of Article